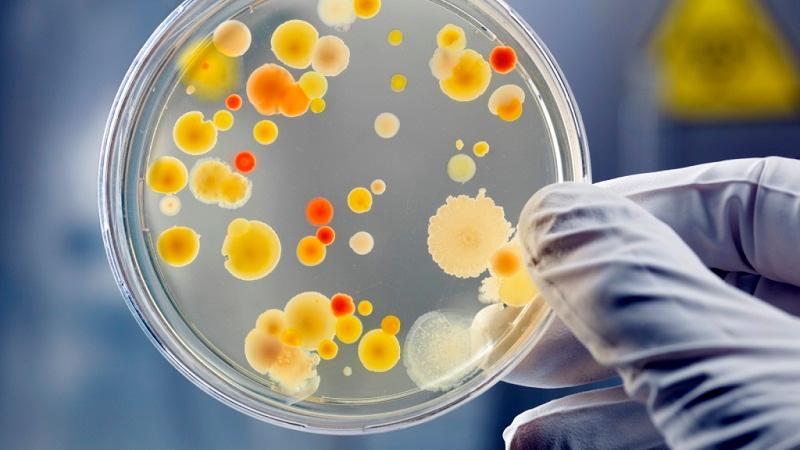
女性用什么精油好呢,女性用什么精油美容最好

接触精油也有几年了,总会被朋友好奇地询问几个问题,比如:女性适合使用什么精油,都有哪些功效呢?
听到这个问题,小花脑子里浮现的第一个答案就是玫瑰精油!

玫瑰精油
对女性来说,玫瑰精油绝对是入手不会亏的那种。
玫瑰精油号称“精油皇后”,它是精油中的王者也是女性精油的最高代表。
为什么这么说,因为玫瑰精油对女性子宫以及分泌系统有着其它精油无法比拟的好处。
年轻女孩儿痛经、经期不适的时候可以用玫瑰精油,中年女性的内分泌失常、子宫需要调养时可以使用玫瑰精油,到了更年期出现的各种身体不适还可以用玫瑰精油。

情绪抑郁、没自信用玫瑰,缺乏女性魅力用玫瑰,肌肤保养美白用玫瑰,滋润抗衰用玫瑰,夫妻深夜交流没兴致还可以用玫瑰……
总之,玫瑰精油可以用在女*生活性**的方方面面。
依兰依兰精油
依兰又名香水树或花中之花,其香气甜美细腻,有着女性特有的柔美感。也被称为穷人的茉莉,是精油界里赫赫有名的“*情催**油”。
可调理生殖系统的诸多问题,是精油中平衡女性荷尔蒙的上选。在有些国家和地区,依兰还被称为“子宫的补药”,是产后女性护理的最佳选择。
可改善经血过少、白带、念珠菌感染及子宫方面的多种病症。还能调和女性身体、平衡荷尔蒙、舒缓生理期疼痛以及保养胸部的功效。

除此外还可以用于面部护肤保养、秀发滋养,据说当地女性会使用依兰依兰精油来使头发更具光泽。
天竺葵精油
玫瑰精油当然好,但是有时候它确实太过昂贵了,那么“平民的玫瑰”——天竺葵精油也是不错的选择。
天竺葵精油与玫瑰精油有很多相似的功效,因此它在女性问题处理上也独具魅力。
尤其是是在处理经期导致的情绪不稳、盗汗、潮红等问题上,有不错的表现。

当然天竺葵精油更多的还是应用在护肤上。有研究表明,天竺葵精油中所含有的有效成分与皮肤具有很强的亲和性。
因此天竺葵精油适合添加在任何护肤品中保养皮肤。
天竺葵精油中含有香茅醇、松油醇、柠檬醛、薄荷酮以及多种微量矿物元素,这对于皮肤来说是非常好的补充营养,让苍白的肌肤变得红润,让人焕发光彩。
茶树精油
茶树精油是一只比较常见且用途广泛的精油。
把茶树精油放在这里是因为它的杀菌、清洁功效,这种能力可以应有在很多地方。
比如皮肤清洁,茶树精油可以清洁油腻皮肤,并且对痘痘有很好的消炎、杀菌功效,是治疗*疮痤**最有效的家庭疗法之一。
比如气味清洁,茶树精油可以消除体臭。其抗菌特性,可以消灭皮肤上引起体臭的细菌。无论是作为护肤油涂抹,还是制成简单的喷雾剂使用,都能在一定程度上达到效果。
比如衣物清洁,茶树精油是少数对「念珠菌」有抑制效果的精油,因此用来清洁内衣裤预防感染再合适不过了。
比如头皮清洁,茶树精油对头发和头皮的健康非常有益。茶树精油具有舒缓干燥、改善头皮剥落和去除头屑的功效。
橙花精油
最后这一只精油,算是小花的夹带的私货,因为小花真的很喜欢橙花精油的味道。
尤其是苦橙花精油,那种芳香怎么闻也闻不够。
热爱苦橙花精油的还有18世纪法国国王路易十五的*妇情**彭派德尔夫人。那时,凡尔赛宫被称作“芳香的宫殿”,出席凡尔赛宫舞会的名媛淑女们,都必须以个人独特的香味来说明自己的个性和品位。彭派德尔夫人将苦橙花精油作为香水使用,带动了苦橙花精油再一次的独领风骚。

说点儿实用的,我认为苦橙花精油最好的功能是对抗忧郁,帮助睡眠。苦橙精油对神经系统有镇定、放松的功能,可以帮助缓和失眠与心跳加快的焦虑感。
尤其是经期前后、怀孕期间、更年期间,总之所有和女人内分泌失调脱不了干系的忧郁症状,苦橙花都是最好的心灵鸡汤。